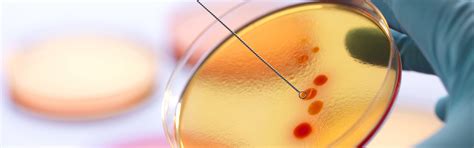

- Teacher: Anke Reich
- Teacher: Hans-Jörg Simon
- Teacher: Peter F. W. Simon
- Teacher: Peter Henselder
- Teacher: Christoph Honisch
- Teacher: Frank Platte
- Teacher: Henrik Rudolf
- Teacher: Katharina Beisel
- Teacher: Nina Friedrich
- Teacher: Anna Gottfried
- Teacher: Peter F. W. Simon
- Teacher: Stefan Weber
- Teacher: Joachim Fensterle
- Teacher: Petra Gawalek
- Teacher: Ramona Kirsch
- Teacher: Ralf Lucassen
- Teacher: Wael Sabra
First lecture on Cell Biology and Microbiology will start at 8:15 a.m. on October 2nd in room 01 EG 005. The password for the moodle course will be announced during the first lecture so that the enrollment in the moodle course will be possible starting from October 2nd (after the lecture).
First lab Course on Cell Biology and Microbiology will start on October 20th in room 10 02 008.
- Teacher: Joachim Fensterle
- Teacher: Petra Gawalek
- Teacher: Ramona Kirsch
- Teacher: Mònica Palmada Fenés
- Teacher: Wael Sabra
- Teacher: Herbert Derksen
- Teacher: Peter Henselder
- Teacher: Björn Neu
- Teacher: Any Preißing
- Teacher: Werner Seuken
- Teacher: Hassan Shafiey
- Teacher: Stefan Weber
- Teacher: Eleydiane Gomes-Vale
- Teacher: Katharina Beisel
- Teacher: Nina Friedrich
- Teacher: Anna Gottfried
- Teacher: Peter F. W. Simon
- Teacher: Stefan Weber
- Teacher: Amir Fahmi
- Teacher: Peter F. W. Simon
- Teacher: Joachim Fensterle
- Teacher: Petra Gawalek
- Teacher: Ramona Kirsch
- Teacher: Mònica Palmada Fenés

- Teacher: Christoph Böhmer
- Teacher: Petra Gawalek
- Teacher: Herbert Derksen
- Teacher: Peter Henselder
- Teacher: Björn Neu
- Teacher: Any Preißing
- Teacher: Hassan Shafiey
- Teacher: Joachim Fensterle
- Teacher: Ralf Lucassen
- Teacher: Wael Sabra
- Teacher: Bhavya Dutta
- Teacher: Joachim Fensterle
- Teacher: Ralf Lucassen
- Teacher: Angelina Ageeva
- Teacher: Julia Erkkilae
- Teacher: Christoph Honisch
- Teacher: Sylvia Moenickes
- Teacher: Hassan Shafiey
- Teacher: Mohamad-Youssef Amer
- Teacher: Christoph Honisch
- Teacher: Sylvia Moenickes
- Teacher: Henrik Rudolf
- Teacher: Christoph Honisch
- Teacher: Henrik Rudolf
- Teacher: Anna Gottfried
- Teacher: Björn Neu
- Teacher: Frank Platte
- Teacher: Any Preißing
- Teacher: Hassan Shafiey
- Teacher: Stefan Weber
The first lecture on "Instrumental Analytics" will take place on September 30st at 10:15 a.m. in room 10 030 004. Enrolment key will be provided at the end of the lecture so that you can enrol in the course. In this first week, there will be no exercises. They will start on October 7th at 12:00 a.m (Group A+B).
- Teacher: Peter Henselder
- Teacher: Mònica Palmada Fenés
- Teacher: Stefan Weber
- Teacher: Peter Henselder
- Teacher: Carlos Perez Bolde
- Teacher: Frank Platte
- Teacher: Peter Henselder
- Teacher: Frank Platte
- Teacher: Thomas Johann Tewes
- Teacher: Peter Henselder
- Teacher: Frank Platte
- Teacher: Any Preißing
- Teacher: Thomas Johann Tewes
- Teacher: Joachim Fensterle
- Teacher: Ralf Lucassen
- Teacher: Wael Sabra
- Teacher: Bhavya Dutta
- Teacher: Joachim Fensterle
- Teacher: Ralf Lucassen
- Teacher: Yudit Ruiz-Sanchez
- Teacher: Wael Sabra
- Teacher: Anna Gottfried
- Teacher: Peter Scholz
- Teacher: Henrik Rudolf
Welcome to the agricultural biotechnology lecture. The first lecture is on Monday, 20 April. I look forward to seeing you there.
To access the lecture PDF, you will need the Moodle key, which will be announced during the lecture.
- Teacher: Wael Sabra

- Teacher: Matthias Kleinke
- Teacher: Axel Huth
- Teacher: Kerstin Koch
- Teacher: Wael Sabra
- Teacher: Bhavya Dutta
- Teacher: Christoph Honisch
- Teacher: Sylvia Moenickes
- Teacher: Frank Platte
- Teacher: Any Preißing
- Teacher: Hassan Shafiey
The first lecture for winter term 2025/26 will be held on Friday, 10th October. NO lecture on 3rd October due to the public holiday.
IMPORTANT: Please enrol to the Moodle course if you want to participate this term. Self-enrolment for students is open from 12 p.m. of 3rd October until the end of day of 17th October. Lecture dates and links will be posted within the Moodle course, so enrolment before 10th October is strongly encouraged.
- Teacher: Luitpold Rudolf Fried
- Teacher: Martin Krehenbrink
- Teacher: Jan Harvey Lindermann
- Teacher: Joachim Fensterle
- Teacher: Ralf Lucassen
- Teacher: Wael Sabra
- Teacher: Peter Henselder
- Teacher: Björn Neu
- Teacher: Any Preißing
- Teacher: Hassan Shafiey
- Teacher: Joachim Fensterle
- Teacher: Ralf Lucassen
- Teacher: Katharina Beisel
- Teacher: Anna Gottfried
- Teacher: Andreas Mohr
- Teacher: Peter F. W. Simon

The course "Academic Methods and Principles" will be offered as concurrent course for the study programs AB, BE, and SAg.
For participation in the module, please enrol in the moodle course BE 4392. All information and course documents will be provided via this moodle course only.
The first lecture will be on April 10th, starting at 8:15 in 01 02 005.
The password to the moodle course will be announced in the first lecture. Enrollment in the moodle course will be possible from April 10th (after the lecture).
Please note that a binding registration via the according tool (to be found in the exercises tab) is necessary for participating in the exercises.
The start of the exercises will be on 17th April.
For questions regarding the exercises or Moodle, please contact Dr. Petra Gawalek.
- Teacher: Opeyemi Adelesi
- Teacher: Christoph Böhmer
- Teacher: Petra Gawalek
- Teacher: Ramona Kirsch
- Teacher: Nadine Merettig
- Teacher: Wael Sabra
- Teacher: Salamatu Joana Tannor
- Teacher: Thomas Johann Tewes
- Teacher: Maren Weller